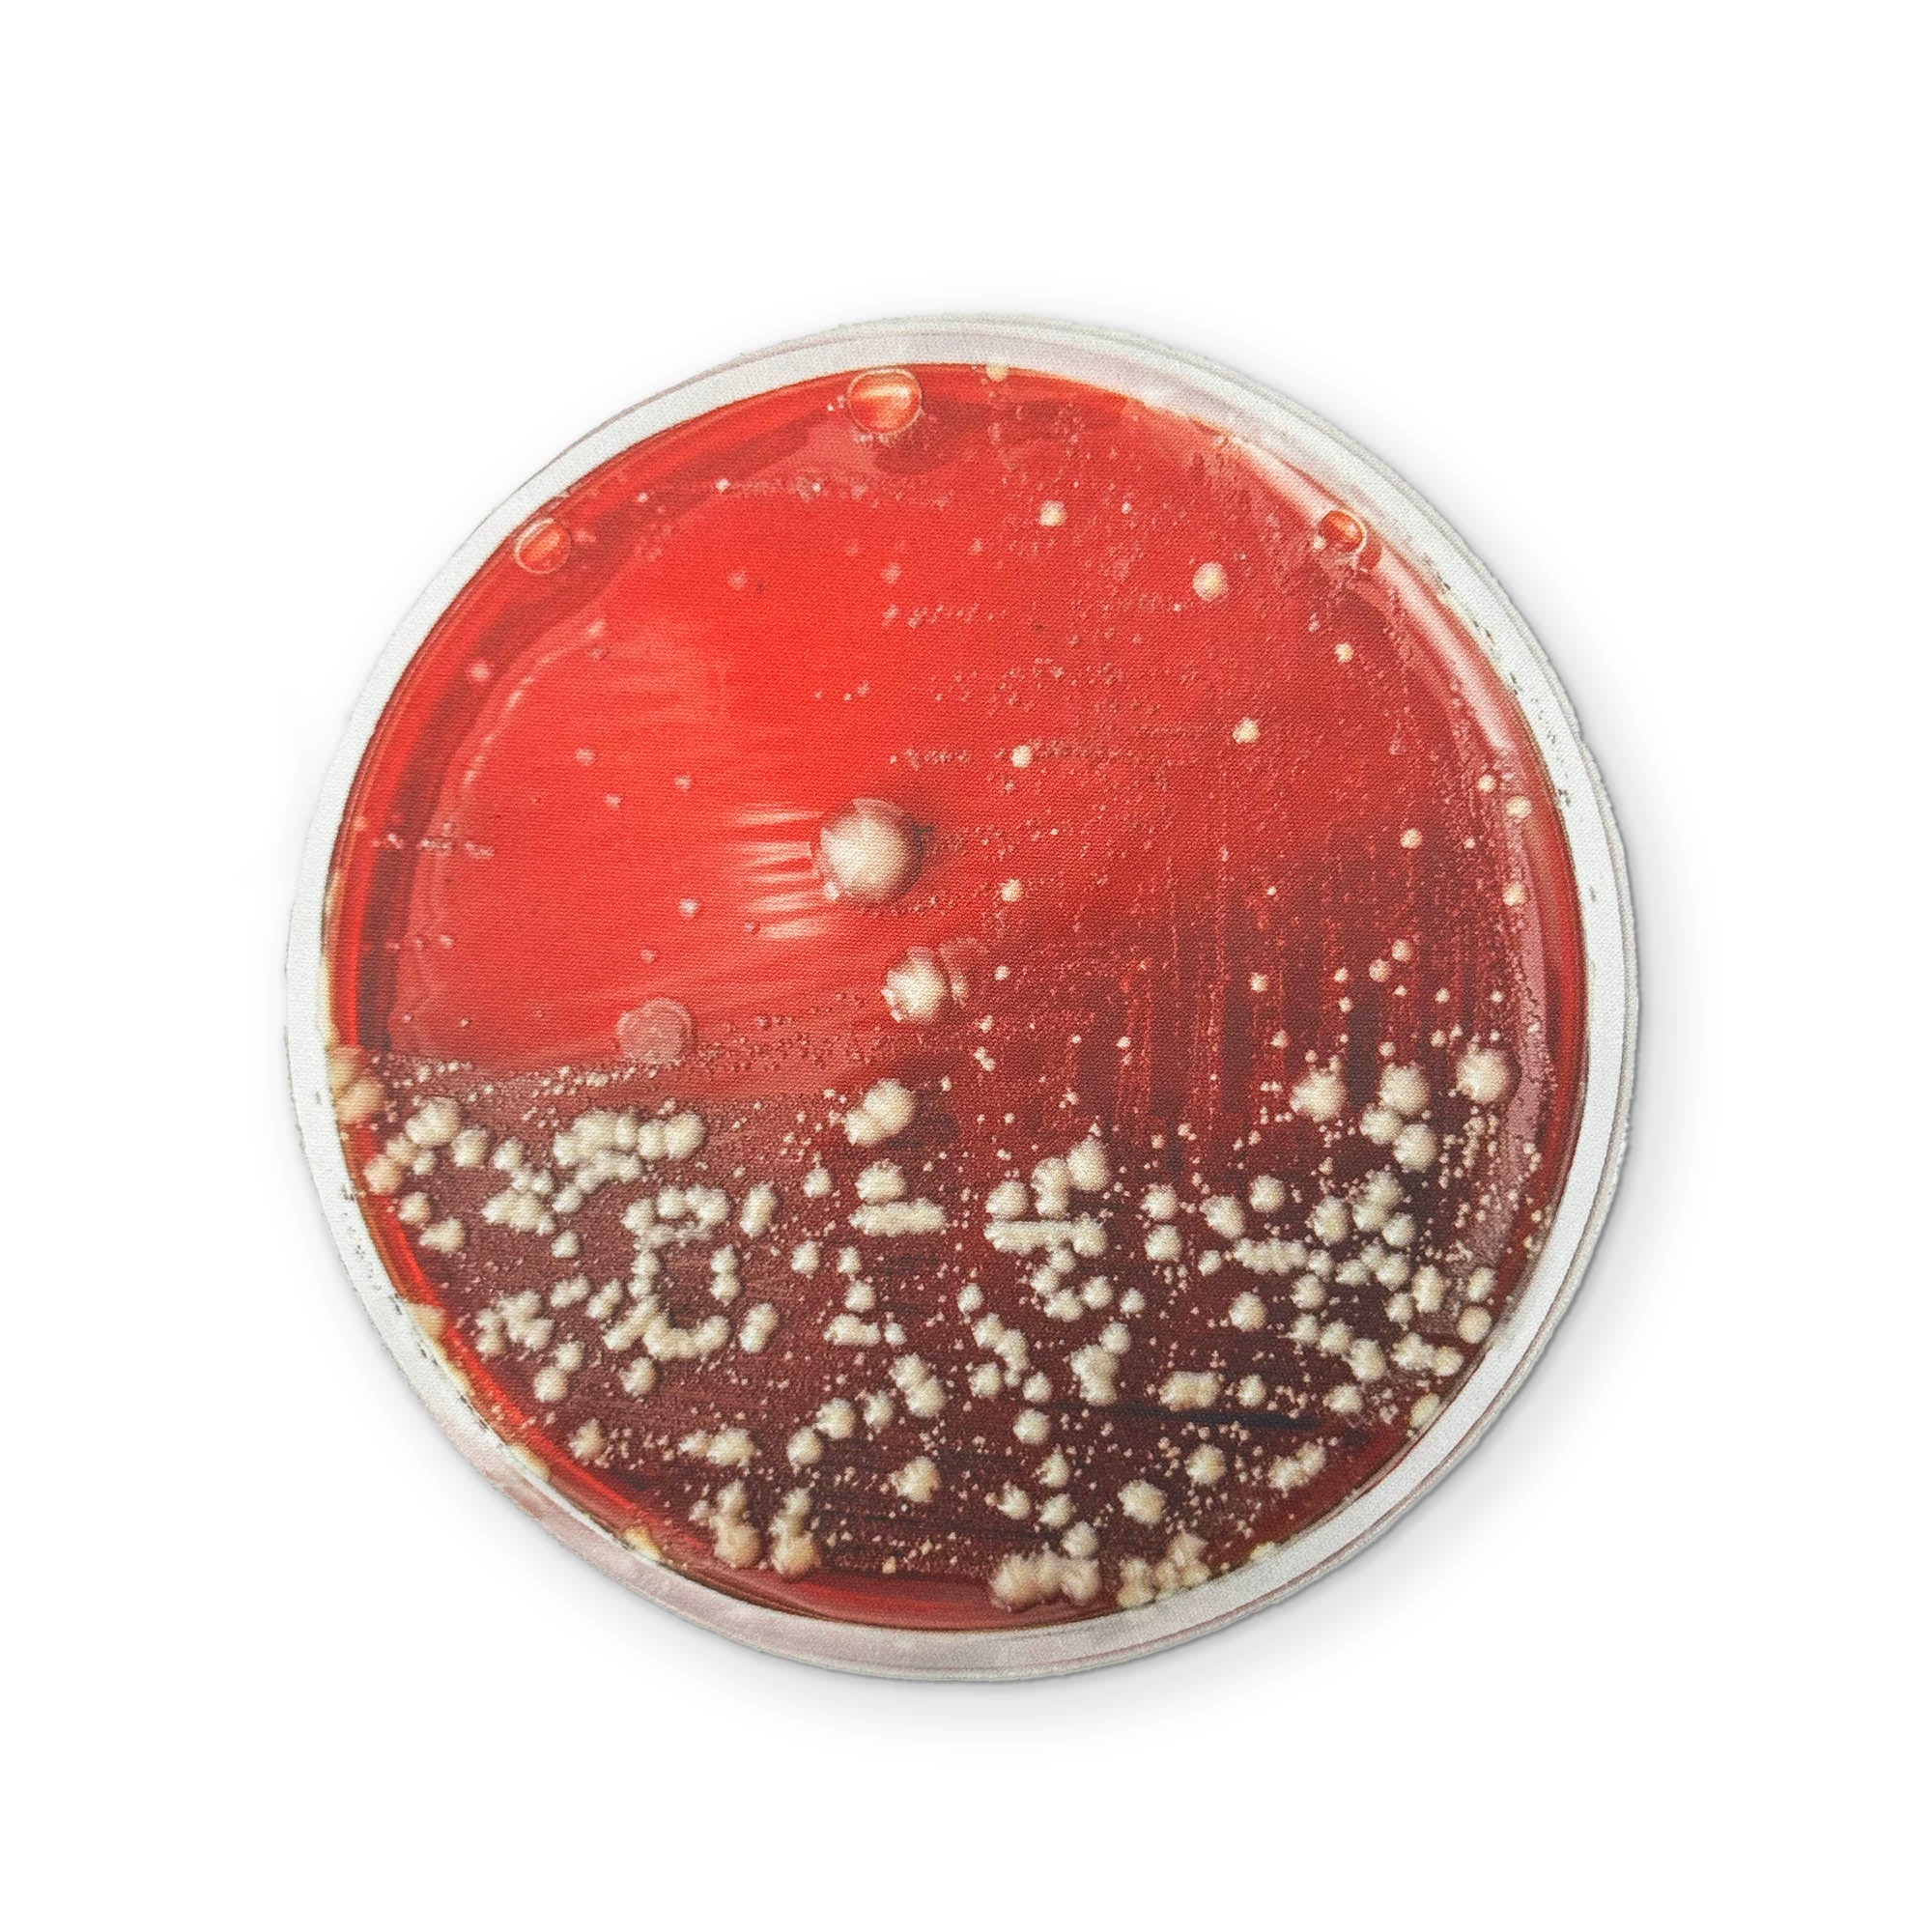
Thumbnail 1

🧀 SWISS CHEESE YOU CAN CLEAN YOUR GLASSES WITH
Holey moly this one's a beaut.
So bright, so smooth, so fragrantly odiferous (not really), the Jinkies Swiss Cheese will have everyone at the dinner party ohhhhhh-ing and ahhhhh-ing at your microfiber charcuterie board.
The Jinkies Swiss Cheese Cloth is great for cleaning off those smudges on your Sunnies Specs & Screens
All Jinkies® branded microfiber cloths are guaranteed to remove Nerdwax from lenses.
DIMENSIONS: 8" X 4.5"
Original: $5.00
-70%$5.00
$1.50Product Information
Product Information
Shipping & Returns
Shipping & Returns
Description
Holey moly this one's a beaut.
So bright, so smooth, so fragrantly odiferous (not really), the Jinkies Swiss Cheese will have everyone at the dinner party ohhhhhh-ing and ahhhhh-ing at your microfiber charcuterie board.
The Jinkies Swiss Cheese Cloth is great for cleaning off those smudges on your Sunnies Specs & Screens
All Jinkies® branded microfiber cloths are guaranteed to remove Nerdwax from lenses.
DIMENSIONS: 8" X 4.5"